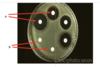

Urinary Tract Infections Flashcards
(72 cards)
How common are UTIs in a GP setting?
- very common
- second only to respiratory problems
Women are much more likley to get a UTI, but what can increase the risk in men?
- enlarged prostate
Bacteriuria is the prescence of bacteria in the urine. What % of patients can be asymptomatic?
- 20% and should not be treated
- treatment can increase the risk of future UTIs
Nosocomial infections, also called health-care-associated or hospital-acquired infections, are infections that patients get whilst in hospital, that they didnt have on admitance to hospital. What % of nosocomial infection are UTIs, and what % of these are due to indwelling catheters
- 40% of nosocomial infections are UTI
- 80% of the 40% are due to indwelling catheters
Can catheters increase the risk of UTI?
- yes
How many different classifications of UTI are there?
- 5
According to the European Association of Urological infection Guidelines what are the 5 classificatins of UTIs?
1 - Uncomplicated UTIs
2 - Complicated UTIs
3 - Recurrent UTIs
4 - Catheter-associated UTIs
5- Urosepsis
According to the European Association of Urological infection Guidelines there are the 5 classificatins of UTIs. What is the definition of an uncomplicated UTI?
- no known anatomical or functional abnormality that predisposes the patient to a UTI
- includes non-pregnant women
According to the European Association of Urological infection Guidelines there are the 5 classificatins of UTIs. What is the definition of an complicated UTI?
- physiological or anatomical abnormality that increases risk of UTI
- pathophysiology that causes complication of renal urinary system
- all men, pregnant women
According to the European Association of Urological infection Guidelines there are the 5 classificatins of UTIs. What is the definition of an recurrent UTI?
- recurrences of uncomplicated and/or complicated UTIs
- frequency of at least three UTIs/year or two UTIs in the last six months
According to the European Association of Urological infection Guidelines there are the 5 classificatins of UTIs. What is the definition of an catheter-associated UTI?
- developing a UTI 48 hours following catheter insertion
According to the European Association of Urological infection Guidelines there are the 5 classificatins of UTIs. What is the definition of an urosepsis UTI?
- life threatening organ dysfunction caused by bacteria present in the blood stream from the urinary tract
What is the most common bacteria that causes a UTIs?
- Uropathogenic Escherichia coli (UPEC)
- strains of E.col that are normally commensal
- if it migrates from GIT to urinary tract, causes UTIs
Proteus mirabilis is a well known urea splitting bacteria. What is urea splitting and what does this commonly cause?
- splits urea, producing ammonia and increasing the pH
- increased pH results in cystal formation
- kidney stones are common with this bacteria
Patients have commensals and pathogenic bacteria, but what 2 things can increase the susceptibility to a UTI?
1 - immunosupression (imbalance beween host and pathogens)
2 - increases virulence from bacteria
Uropathogenic Escherichia coli (EPEC) is the leading cause of UTIs. They posses 2 virulence factors related to their structure that help them infect patients, what are they?
1 - flagella = allow them to move
2 - pilli = adhere to and invade epithelial cells

Uropathogenic Escherichia coli (EPEC) is the leading cause of UTIs. EPEC posses flagella which allow them to be motile, and pilli which allow them to stick and invade to epithelial cells. What is stage 1 of a UTI?
- contamination of the periurethral area
- relates to tissue around the urethra

The first stage of a UTI is contamination of the periurethra (area surrounding the urethra). Once contaminated, what is the second stage of a UTI?
- colonisation of the urethra and migration to the bladder

Uropathogenic Escherichia coli (EPEC) is the leading cause of UTIs. EPEC posses flagella which allow them to be motile, and pilli which allow them to stick and invade to epithelial cells. Stage 1 of a UTI is when the UPEC contaminates the periurethra (area surrounding the urethra). Once contaminated, the second stage of a UTI is colonisation of the urethra and migration to the bladder. What is the 3rd stage of a UTI?
- UPEC adhere and infiltrate the epithelial of the bladder due to pilli
- inflammation occurs, specifically neutrophil infiltration

Uropathogenic Escherichia coli (EPEC) is the leading cause of UTIs. EPEC posses flagella which allow them to be motile, and pilli which allow them to stick and invade to epithelial cells. Stage 1 of a UTI is when the UPEC contaminates the periurethra (area surrounding the urethra). Once contaminated, the second stage of a UTI is colonisation of the urethra and migration to the bladder. Once the UPEC adhere and infiltrate the epithelial of the bladder due to pilli inflammation occurs, specifically neutrophil infiltration. What is the UPEC then able to do?
- avoid bodies immune system due to virulence factors
- multiply and form biofilms
- release of toxins and protease (degrade proteins)

Uropathogenic Escherichia coli (EPEC) is the leading cause of UTIs. EPEC posses flagella which allow them to be motile, and pilli which allow them to stick and invade to epithelial cells. Stage 1 of a UTI is when the UPEC contaminates the periurethra (area surrounding the urethra). Once contaminated, the second stage of a UTI is colonisation of the urethra and migration to the bladder. Once the UPEC adhere and infiltrate the epithelial of the bladder due to pilli inflammation occurs, specifically neutrophil infiltration. UPEC are then able to avoid bodies immune system due to virulence factors and multiply, forming biofilms (especially in catheters) which allows the UPEC to then release toxins and proteases (degrade proteins), further damaging epithelial. In some instances where can the UPEC then travel to?
- kidneys, where they can colonise

What is the term given when a pathogen has infected the urinary tract and travelled to the kidneys and began to colonise?
- pyelonephritis

Pyelonephritis is when a pathogen has infected the urinary tract and travelled to the kidneys and began to colonise. What can then occur?
- infection of host tissue and damage by bacterial toxins
- bacteremia, where the pathogen enters the blood
Everyone who has a positive urine dipstick should have a urine culture, except who?
- non-pregnant woman presenting with cystitis